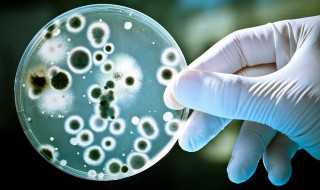
细菌的保存方法（细菌的保存方法甘油名称）

文章资讯
苏州工业园区星澄学校课后服务问题回答
星澄学校课后服务的老师以我们自己的老师为主,而且,我们还会校外聘请具备相应资格的专业人员参与校内课后服务呢!
苏州工业园区朝前路实验学校课后服务相关信息
课后服务由本校教职工承担,也可积极争取具备资质的社会专业人员或者家长志愿服务力量。
2021吴江区民办普通高中综合评价招生信息提醒
民办普通高中综合评价招生工作正在开展,请符合以下条件的有意愿参加的考生,及时与相关学校联系。
2021年昆山中考专科学校最低投档线是多少?
2021年昆山市中招第二、三阶段最低录取分数线出炉啦!专科学校最低投档线是多少?详细那就看看本文吧!
2021吴江中考第一批次没有录取怎么办 吴江中考入学批次是什么
考生至第一批次第3阶段统招阶段结束,尚未被录取批次学校,且考生成绩位次不低于该民办普通高中学校统招计划最低控制分数线的可报考民办学校。
2021吴江区综合评价招生的民办高中有哪些?
民办普通高中综合评价招生工作正在开展,请符合以下条件的有意愿参加的考生,及时与相关学校联系。
2021常熟中考录取时间安排(2021常熟中考提前录取)
2021年苏州高考分数线陆续公布,录取工作已经开始,小编整理了一份日程安排,一起来看看!
2021年常熟四星级高中指标生分配一览表
以全市参加中考考生的成绩总分排名第1900名考生的中考成绩总分划定省中和市中的最低控制线;以全市参加中考考生的成绩总分排名第5200名考生的中考成绩总分划定其他四星级普通高中最低控制线。
2021年苏州中学提前批次录取分数线(苏州中学录取分数线预测)
相城区教育局召开全区教育工作会议,小编了解到2021年相城区中招提前批次录取分数线公布,赶紧来看看吧~
2021相城区中考提前批次录取分数线汇总
相城区教育局召开全区教育工作会议,小编了解到2021年相城区中招录取分数线公布,赶紧来看看吧~
相城中学提前批次录取分数线2021(相城中学高中部分数线)
相城区教育局召开全区教育工作会议,小编了解到2021年相城区中招提前批次录取分数线公布,赶紧来看看吧~
2021年相城区中考师范教育类学校录取分数线一览
相城区教育局召开全区教育工作会议,小编了解到2021年相城区师范类学校录取分数线公布,赶紧来看看吧~
2021年相城区普通高中创新班录取分数线一览
相城区教育局召开全区教育工作会议,小编了解到2021年相城区中招提前批次录取分数线公布,赶紧来看看吧~
有三令五申的典故是谁 三令五申出自哪个时期及其典故
1、三令五申说的是孙武。2、三令五申(拼音:sān lìng wǔ shēn)是一个汉语成语,最早出自西汉·司马迁《史记·孙子吴起列传》。3、该成语意思是多次命令和告诫。成语结构是联合式,在句中作谓语;含褒义。
细菌的保存方法(细菌的保存方法甘油名称)
1、细菌保存于穿刺培养物中:一般细菌保存于穿刺培养物可以维持两年。具体方法如下:用灭菌接种针挑取分散良好的单菌落,针缓慢穿过琼脂到达瓶底,连续几次,盖上瓶盖拧紧,做好标记。室温下存放于暗处。(最好一点可以将瓶盖放松,在适
安全生产月演讲稿 安全生产月演讲稿1000字
1、大家好!2、今天,我演讲的题目是《为了每一个鲜活的生命》。幸福是什么?有人说。吃穿不愁,衣食无忧,就是幸福;有人说,工作舒适,心情愉悦,就是幸福;有人说,金榜提名,建功立业,就是幸福;还有人说,花前月下,情投意合,这
安全教育第一课观后感 安全教育第一课观后感500字
1、这天,我看了一个安全教育片,主要讲的地震、游泳、交通事故、火灾来袭时,怎样保护自身安全。2、当地震来临时,如果是在家里,必须要躲在卫生间或坚硬的床底下,用柔软的枕头保护头部,千万不好躲在窗户底下,更不好从窗户上往下跳
个人爱好及特长怎么写 个人爱好及特长怎么写15字
个人爱好及特长的描写需要围绕求职意向展开,同时要能体现于工作,爱好越具体越好,最好写上一两项体育爱好,切记不要无中生有等。1、围绕求职意向如果想做技术的,就写上网页设计,趴技术论坛,参加技术聚会,在知乎、百度百科上给人回
打破常规作文 打破常规作文800字议论文
1、涓涓细流,绕过千山万阻,汇成江河,只为了流入大海,回头看,曲流织成网;细细的藤枝,缠绕着枝干,螺旋生长,只为了生存,览全体,绘出美妙的螺旋结构。自然中的万物,无一不打破常规,为了自己的目标,而挑战自我,绽放人生光彩。
胆小的我作文(胆小的我作文600字)
1、我是一个非常胆小的人。每次,只要我一个人呆在家里,都觉得有什么地方不对,老是想着后面有一双眼睛一直盯着我,让我的心里觉得很害怕。2、晚上,我看了电影《鬼吹灯》,里面的剧情太惊悚了,僵尸披头散发,红红的舌头,铜铃的大眼
过中秋节作文300字 过中秋节作文300字小学三年级
1、中秋节到了。我和妈妈提着礼物去外公家玩。我们来到外公家。可爱的小狗“晶晶”摇着尾巴,跳跃着欢迎我们,然后跳在我身上。2、早晨六点,我和外公、哥哥、小狗在门口玩。妈妈和外婆到庄稼地里给菜浇水,小狗跑来跑去,在追赶一只蚂
执子之手与子偕老全诗(执子之手与子偕老全诗词)
1、《击鼓》击鼓其镗,踊跃用兵。土国城漕,我独南行。从孙子仲,平陈与宋。不我以归,忧心有忡。爰居爰处?爰丧其马?于以求之?于林之下。死生契阔,与子成说。执子之手,与子偕老。于嗟阔兮,不我活兮。于嗟洵兮,不我信兮。
财务出纳个人工作总结 财务出纳个人工作总结及不足
1、参加工作后转眼两个月过去了,作为一个刚参加工作的新员工,总结2019年上半年的工作以予在下半年年中更好的发现自己,完善自我,在这半年里通过领导和各位同事对我的帮助和关心,让我也清楚的认识到了自己在工作中的不足,从而也
说好普通话手抄报内容资料
1、普通话是以北京语音为标准音,以北方话(官话)为基础方言,以典范的现代白话文著作为语法规范的现代标准汉语。“普通话”一词早在清末就出现了,1906年,研究切音字的学者朱文熊提出了“普通话”的名称,而且明确地给“普通话”
淳淳教诲的意思是(淳淳教诲意思是什么)
1、淳淳教诲:恳切、耐心地启发开导。2、历历在目:指远方的景物看得清清楚楚,或过去的事情清清楚楚地重现在眼前。 3、亲密无间:形容关系十分密切,没有丝毫隔阂。4、呕心沥血:比喻用尽心思。多形容为事业、工作、文艺创作。
鹦鹉灭火文言文翻译 鹦鹉灭火文言文翻译及注释视频
有一只鹦鹉飞到了另一座山,在那里休息,山中的飞禽走兽都很喜欢它。鹦鹉虽然觉得这座山让它很快乐,但不是它长久停留的地方,便飞走离开了。飞禽走兽都很舍不得它。
国庆中秋手抄报 国庆中秋手抄报内容简短
1、首先在顶部写上“国庆中秋”的标语,再画上小男孩、月亮。2、然后在图中画上国旗、天安门、兔子,星星和写字框。3、之后把画好的元素涂上相应的颜色。4、最后在写字框内写上文字即可。
小儿垂钓原文(小儿垂钓原文及解释翻译)
蓬头稚子学垂纶,侧坐莓苔草映身。路人借问遥招手,怕得鱼惊不应人。全诗意思是:一个头发蓬乱的小孩子正在学垂钓,侧身坐在青苔上绿草映衬着他的身影。遇到有人问路,他老远就招着小手,因为不敢大声应答,唯恐鱼儿被吓跑。
少年闰土全文 少年闰土全文免费阅读
深蓝的天空中挂着一轮金黄的圆月,下面是海边的沙地,都种着一望无际的碧绿的西瓜。其间有一个十一二岁的少年,项带银圈,手捏一柄钢叉,向一匹猹用力地刺去。那猹却将身一扭,反从他的胯下逃走了。
蝙蝠的简笔画 蝙蝠的简笔画怎么画
1、首先画蝙蝠的身体。2、然后画蝙蝠的眼睛。3、接着画蝙蝠的翅膀。4、最后把画好的元素涂上蓝色即可。